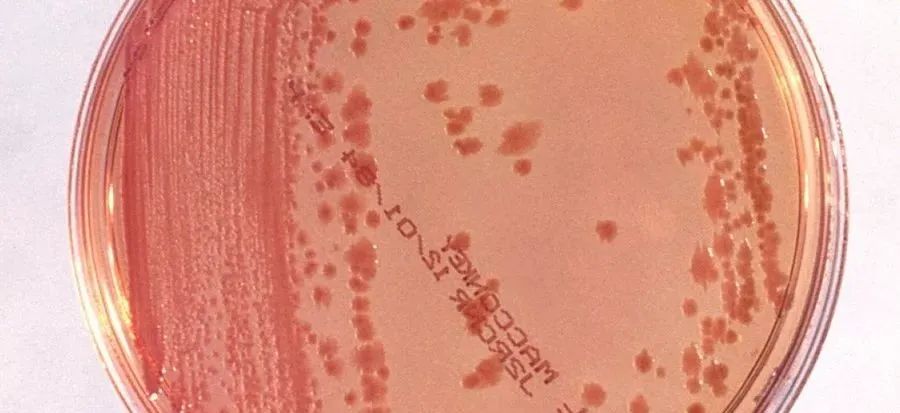

国产女人高潮毛片-伊人情涩网-亚洲欧美日韩在线精品2024-久久精品AⅤ无码中文字字幕-人妻日本无中文字幕无码
地址:山东省.泰安市.泰前
电 话:0538-8505866
传 真:0538-8505966
财富热线:18660886576
1、鳗弧菌,革兰氏阴性菌,最适温度25℃,可耐受的pH值范围为5-11,盐度范围5‰-50‰,0%的淡水不生长,能利
用单糖或寡糖,在TCBS培养基形成1-2mm以上的黄色菌落。
表现症状:病虾活动力减弱,食欲下降,个体消瘦,头胸甲心区附近呈白色或浅桔红色,血淋巴液稀薄、混浊、不能
凝固。因病虾步足、游泳肢及尾扇呈鲜红色。

2、溶藻弧菌,革兰氏阴性菌,可耐受的pH值范围为6-8.5,盐度范围5‰-50‰,0%的淡水不生长,能利用单糖或寡
糖,在TCBS培养基形成2-3mm以上的黄色菌落。
3、副溶血弧菌,革兰氏阴性菌,最适温度30-37℃,可耐受的pH值范围为6-8.5,嗜盐菌20‰-30‰繁殖较快,
5‰以下停止生长,能利用蔗糖和乳糖,在TCBS培养基形成2-3mm以上的蓝绿色菌落。
4、非01群霍乱弧菌,革兰氏阴性菌,可耐受的pH值范围为6-8.5,淡水及高盐度都能生长及繁殖,能利用单糖或寡
糖,在TCBS培养基形成2-3mm以上的黄色菌落。
表现症状:行动呆滞,时而浮头或在水面上翻滚;眼球肿胀,由黑变暗以至溃烂仅留眼柄,随着病情加重全身肌肉
发白,一般在一周内死亡。
5、坎贝氏弧菌,革兰氏阴性菌,最适温度15-35℃,可耐受的pH值范围为5-10, 10‰-50‰繁殖较快,淡水及高盐
度都能生长及繁殖,能利用单糖或寡糖,在TCBS培养基形成0.5-2.0mm的绿色菌落。
表现症状:病虾活动力减弱,在池边水面缓慢游动,或沉底不动,有时作旋转游动或垂直游动;对外界的惊扰反应
迟钝;食欲减退或停止吃食。个体消瘦,甲壳与肌肉间空隙大;头胸甲心区上方由原来的清色透明变为白色,后期
变为淡桔红色,形状为三角形。主要的症状是附肢变红,游泳足较早变红,以后步足及尾肢也呈鲜红色。
6、哈维氏弧菌,革兰氏阴性菌,最适温度37℃,可耐受的pH值范围为5-9.5盐度范围20‰-30‰,0%的淡水不生长,
能利用单糖或寡糖,在TCBS培养基形成1-2mm以上的黄色菌落。
表现症状:发病初期,虾活动能力下降,沉伏底部,大多随水流翻滚,不摄食或摄食少,发病早期不发光,濒死时
或死亡后会发出荧光。
弧菌的胞外产物(如酯酶、蛋白酶、磷酸酯酶、溶血素和几丁质等)主要是通过产生蛋白酶或者促使机体组织释放
蛋白酶而造成组织溶解,具体表现形式如下:
2、妨碍对虾血液凝固
3、破坏对虾体组织、引发炎症
4、降低对虾免疫力
1、低溶解氧环境(连续阴雨天气,倒藻,养殖密度过高,增氧设备不足);
2、底质恶化,虾自身免疫力下降;
3、盐度,3‰-20%中低盐度水体中;
4、水体中有机物丰富。
1.从清塘开始清塘的时候先晾干塘底,撒一些生石灰让太阳暴晒一个星期左右,再蓄水,蓄水之后用漂白粉漂一
下。
3.放苗后3天检测一次弧菌,在天气变化时,尤其重视做到两2天一测,做到早发现早预防,因为弧菌的繁殖速度超
快,一个弧菌分裂繁殖一代,(2个弧菌)也只需要10分钟。一个池塘水体中肯定不止一个弧菌,有时候我们感觉可能
会超标时,建议在检测的同时,就先预防加以控制,因为很可能在我们检测结果还没出来的那10几个小时里弧菌不
断繁殖虾就开始发病了。
4.控制弧菌,尽量采用菌相+藻相+蛭弧菌的生物控制方案。不到非用不可,尽量减少消毒剂的使用。大量的培养
有益菌让益菌来控制有害菌的繁殖。
6.养殖动物和养殖水体是一个有机整体 ,我们在处理好水质的同时,一定不要忽略养殖动物本身,本身体质好,抵
抗力就强 ,携带的病原菌相对较少,反之则多。在养殖过程中会随代谢物排入水体污染水质 ,增加弧菌爆发的几
率,因此在处理水环境的同时加强内服是关键。
声明:本公众号未注明出处的转载文章是出于传递更多信息之目的。若有未注明出处或标注错误或侵犯了您的合法
权益,请我们联系,我们将及时更正、删除,谢谢!